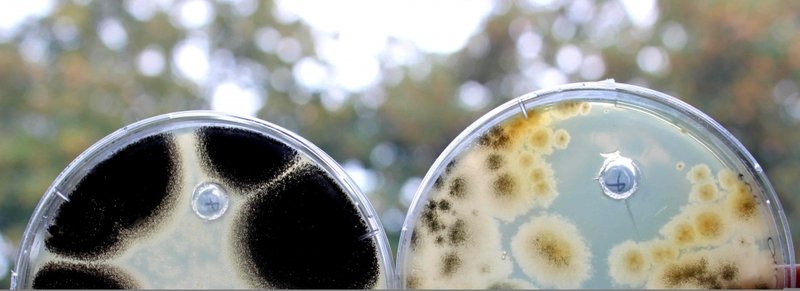

Platanes
Des étudiants toulousains inventent une méthode de lutte contre le chancre coloré
BRANCOTTE V.
12 septembre 2014 15:50 (2575)

Le concours international de biologie synthétique IGEM organisé aux Etats-Unis par le Massachusetts Institute of Technology (MIT) réunit chaque année plus de 200 équipes d'étudiants en biologie venues du monde entier. Cette année, une équipe française constituée d'étudiants de l'INSA de Toulouse et de l'université Paul-Sabatier tentera de convaincre le jury avec une méthode d'éradication biologique du chancre coloré par "trithérapie de biofongicide". Voies navigables de France (VNF) et le ministère du Développement durable ont déjà manifesté leur intérêt.....
Nommé SubtiTree, le projet des étudiants toulousains est basé sur l'utilisation d'une bactérie, Bacillus subtilis, naturellement présente dans la sève de l'arbre. "Le projet comporte trois étapes, explique Pierre Reitzer, membre de l'équipe. La première étape est de rendre la bactérie capable de viser une cible, en l'occurrence Ceratocystis platani, le chancre coloré. Il faut ensuite qu'elle soit capable de se fixer sur le champignon. Une fois fixée, elle le détruira en produisant un cocktail de trois fongicides".
La méthode est encore en phase de test mais les premiers résultats ont amené VNF et le Ministère à participer à hauteur de 27.000 euros au financement du projet. Si SubtiTree s'avère opérationnel, l'injection de 10 ml de liquide dans chaque arbre rendra inutile les abattages préventifs, fort impopulaires et destructeurs d'un paysage classé au patrimoine mondial de l'Unesco.
L'équipe se rendra à Boston, Massachussetts (Etats-Unis) fin octobre pour présenter son projet devant un jury de scientifiques internationaux. S'ils ne décrochent pas le premier prix - un Lego d'acier de 30 cm de long! -, ils espèrent bien gagner le prix "Environnement". Victoire ou pas, des membres de l'équipe continueront à travailler sur SubtiTree dans le cadre de leurs thèses...